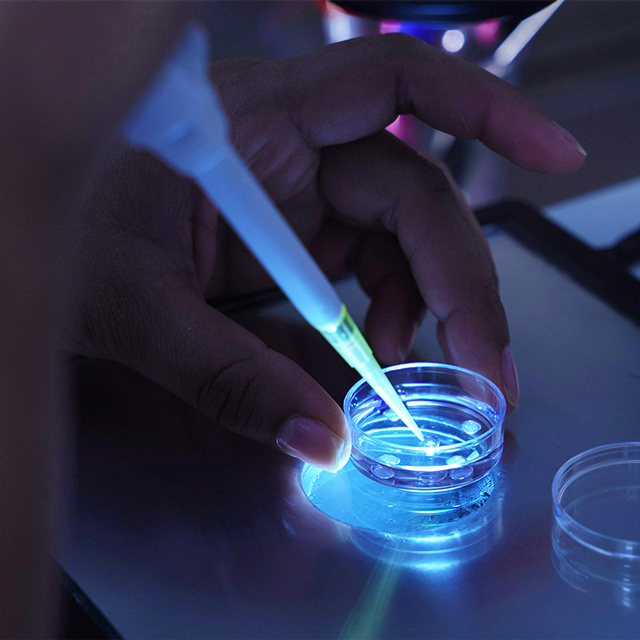
Instalaciones laboratorio EmbrionajeLife

01
01
Laboratorio y biotecnología (FIV)
- Producción In Vitro (FIV): Maduración y fertilización de embriones con protocolos personalizados por raza.
- Maquila Técnica: Procesamiento especializado para laboratorios y profesionales externos.
- Criopreservación: Congelación avanzada de embriones y ovocitos.